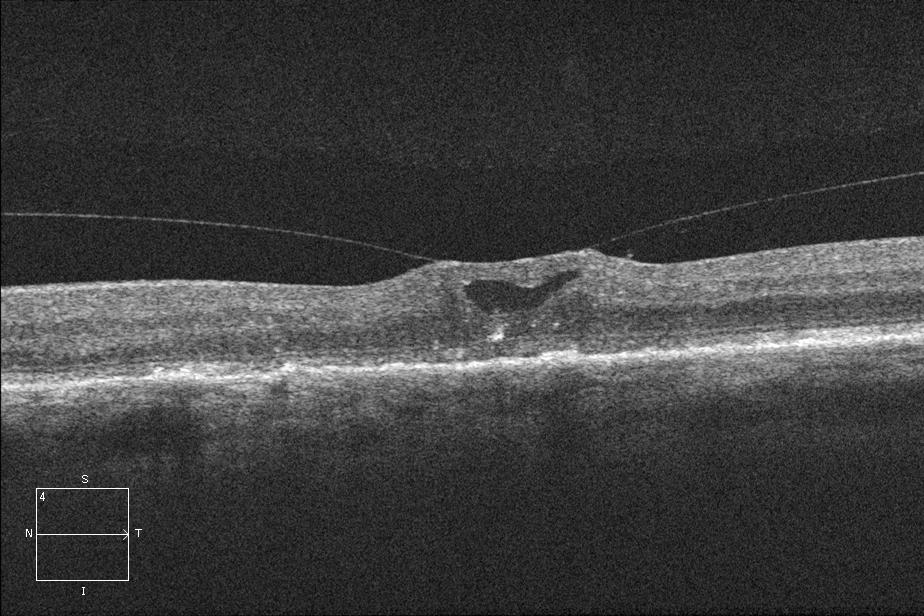
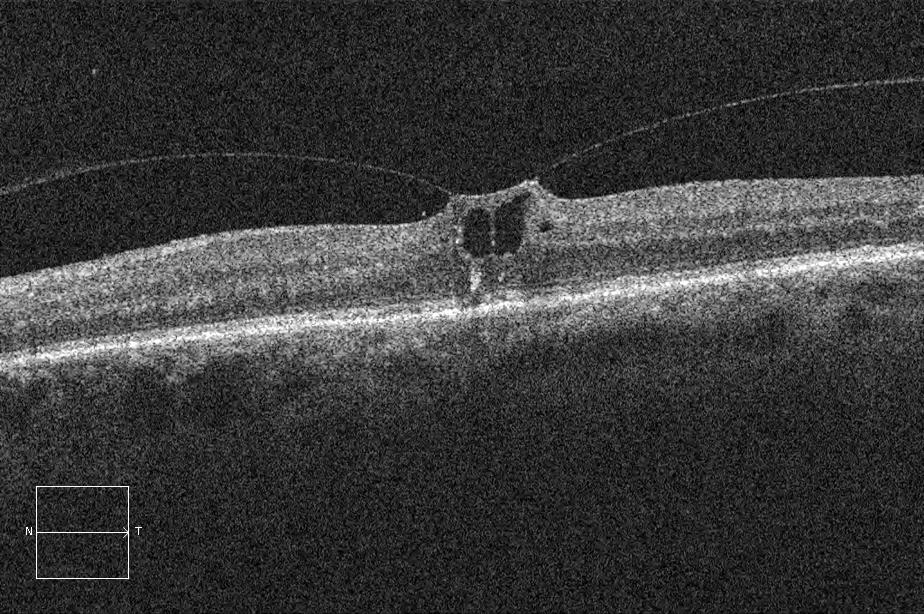

Vitreomacular Traction Syndrome
All content on Eyewiki is protected by copyright law and the Terms of Service. This content may not be reproduced, copied, or put into any artificial intelligence program, including large language and generative AI models, without permission from the Academy.
Vitreomacular traction (VMT) syndrome is a potentially visually significant disorder of the vitreoretinal interface characterized by an incomplete posterior vitreous detachment with the persistently adherent vitreous exerting tractional pull on the macula and resulting in morphologic alterations and consequent decline of visual function.
Disease Entity
International Classification of Disease (ICD)
ICD-9:
- 379.27 Vitreomacular adhesion or Vitreomacular traction
ICD-10:
- H43.821 Vitreomacular adhesion, right eye
- H43.822 Vitreomacular adhesion, left eye
- H43.823 Vitreomacular adhesion, bilateral
- H43.829 Vitreomacular adhesion, unspecified eye
Disease
Vitreomacular traction (VMT) syndrome is a disorder of the vitreo-retinal interface characterized by:
(i) an incomplete posterior vitreous detachment (PVD),
(ii) an abnormally strong adherence of the posterior hyaloid face to the macula and
(iii) anteroposterior traction exerted by the syneretic vitreous pulling at adherent sites on the macula causing morphologic and often functional effects.
History
In 1953, Irvine described a vitreous tug syndrome caused by vitreous incarceration at the corneal wound site following intra- and extra-capsular cataract extraction leading to cystoid macular edema (CME) from vitreomacular traction.[1] In 1967, Jaffe described ‘vitreoretinal traction syndrome’ in 14 patients as a distinct entity. The condition he described mostly affected phakic patients, lacked multicystic macular lesions and fluorescein leakage, and demonstrated vitreoretinal adherence - features differentiating it from Irvine’s syndrome.[2] Reese et al. studied macular changes in VMT and reported Irvine’s and Jaffe’s descriptions as parts of a spectrum of disease, with aphakia predisposing to more severe changes via additional traction.[3] Histopathologic studies by Reese et al. confirmed ‘vitreomacular traction syndrome’ and showed partially detached posterior hyaloid with persistent attachment to the internal limiting membrane (ILM) in the foveal region.[4]
Definitions
Optical coherence tomography (OCT) has allowed better understanding and visualization of the vitreomacular interface. Vitreomacular adhesion (VMA) and vitreomacular traction (VMT) are two of the many entities along the spectrum during the course of an incomplete posterior vitreous detachment, also referred to as anomalous PVD. Recently, OCT-based anatomic definitions and classifications have been proposed by the International Vitreomacular Traction Study Group to define these entities as below:[5]
| Entity | OCT-based definition | Additional features | Symptom | Corresponds to full thickness macular hole (FTMH) stage: |
|---|---|---|---|---|
| Vitreomacular adhesion (VMA) | The following must be present on at least one OCT B-scan image: (i) Partial vitreous detachment as indicated by elevation of cortical vitreous above the retinal surface in the perifoveal area (ii) Persistent vitreous attachment to the macula within a 3-mm radius from the center of the fovea (iii) Acute angle between posterior hyaloid and inner retinal surface (iv) Absence of changes in foveal contour or retinal morphology |
None | None | Stage 0 (Other eye should have full thickness macular hole) |
| Vitreomacular traction (VMT) | The following must be present on at least one OCT B-scan image: (i) Partial vitreous detachment as indicated by elevation of cortical vitreous above the retinal surface in the perifoveal area (ii) Persistent vitreous attachment to the macula within a 3-mm radius from the center of the fovea (iii) Acute angle between posterior hyaloid and inner retinal surface (iv) Presence of changes in foveal contour or retinal morphology (distortion of foveal surface, intraretinal structural changes such as pseudocyst formation, elevation of fovea from the retinal pigment epithelium (RPE), or a combination of any of these three features) (v) Absence of full thickness interruption of all retinal layers |
Foveal pseudocyst, macular thickening, retinal capillary leakage (typically isolated VMT alone does not cause leak on fluorescein angiography), macular schisis, cystoid macular edema, retinal detachment |
Reduced or distorted vision |
Stage 1 (VMT only, i.e. impending macular hole) OR Stage 2 (VMT with small/medium FTMH) OR Stage 3* (VMT with medium/large FTMH) |
[*One study suggests that stage 3 FTMH may not be associated with VMT as the vitreous was noted to be detached from the fovea in all cases.[6]]
| Entity | OCT-based classification |
|---|---|
| Vitreomacular adhesion (VMA) | (i) Focal: Width of attachment ≤1500 μm (ii) Broad: Width of attachment >1500 μm |
| (i) Concurrent: Associated with other macular abnormalities (e.g. age-related macular degeneration, retinal vein occlusion, diabetic macular edema) (ii) Isolated: Not associated with other macular abnormalities | |
| Vitreomacular traction (VMT) | (i) Focal: Width of attachment ≤1500 μm (ii) Broad: Width of attachment >1500 μm |
| (i) Concurrent: Associated with other macular abnormalities (e.g. age-related macular degeneration, retinal vein occlusion, diabetic macular edema) (ii) Isolated: Not associated with other macular abnormalities |
Many authors have identified a subset of VMT called vitreofoveal traction (VFT) where the vitreomacular attachment is limited to a focal foveal region (as shown in the figure above) differentiating it from classic VMT. Prior classifications of VMT are summarized in the section on OCT presented above.
Epidemiology
The prevalence of isolated VMT syndrome is reported to be 22.5 per 100,000 population. The annual incidence of isolated VMT syndrome is 0.6 per 100,000 population. The prevalence and incidence of VMT associated with diabetic retinopathy, diabetic macular edema, age-related macular degeneration, and other macular diseases (concurrent VMT) is much higher.[7] Overall, about 1.5% of the population is estimated to have eye diseases caused by or associated with VMA.[7] The incidence of VMA diagnoses is expected to increase with widespread use of OCT and availability of pharmacologic therapies.
Pathophysiology
With age, the vitreous gel undergoes liquefaction forming pockets of fluid within the vitreous (synchysis) which leads to a contraction or condensation (syneresis) of the vitreous. With loss of vitreous volume, there is a tractional pull exerted at sites of vitreoretinal and vitreopapillary attachments by means of the condensing dense vitreous cortex.
At the same time, there is weakening of these attachments between the vitreous and the internal limiting membrane (ILM) and it is proposed that detachment of the posterior hyaloid proceeds in the following sequence:[6][8][9]
- (i) Perifoveal region (possibly, temporal followed by nasal)
- (ii) Superior and inferior vascular arcades
- (iii) Fovea
- (v) Mid-peripheral retina
- (vi) Optic disc (when vitreous is detached fully from the optic disc, commonly associated with the Weiss ring, it is called a complete PVD)
When anterior vitreous pull and weakening of attachments occur synchronously, a normal posterior vitreous detachment (PVD) occurs. However, when these occur asynchronously (tractional component preceding or proceeding faster than the vitreoretinal detachment), an anomalous PVD develops which can result in VMT and other vitreoretinal diseases. As noted in the table above, the VMT progression can correlate with various stages of FTMH.[6]
The vitreous is most firmly attached to the retina in areas where the ILM is the thinnest including
- anteriorly at the vitreous base,
- surrounding lattice degeneration,
- enclosed ora bays, and retinal tufts; and
- posteriorly along major retinal vessels,
- optic disc margins, and
- certain areas of the macula – mainly to the foveola (500 μm diameter area in the center of macula) and the margin of the fovea (circumference of the 1500 μm diameter fovea).[9][10][11]
This partly explains the persistence of foveal attachment in VMT. When the posterior hyaloid detaches from the posterior pole and macula, but remains attached at the fovea, the detached portion of posterior hyaloid lies anterior to the plane of vitreofoveal attachment. This leads to a static anterior traction due to the elastic properties of the vitreous and results in foveal elevation or distortion. Additionally, ocular rotations occurring with eye movements may exert dynamic anterior traction at the site of the vitreofoveal attachment. Such dynamic traction seems to be of greater importance than the static traction in VMT.[9] A smaller diameter of vitreofoveal adhesion is associated with higher tractional stress (force per unit area) resulting in greater foveal deformation.[12] A vitreofoveal adhesion ≤500 μm is associated with vitreofoveolar traction syndrome (in addition to microhole, lamellar hole, and full-thickness macular hole), while a vitreofoveal adhesion approximating 1500 μm is associated with vitreomacular traction syndrome (in addition to exacerbation of concurrent diseases including tractional diabetic macular edema and exudative age-related macular degeneration).[9] Although still debated, both anteroposterior (vitreo-macular) and tangential (epiretinal/vitreoschisis remnants) tractional forces are thought to contribute to VMT.
The anomalous adherence of the posterior hyaloid to the retina can be either a primary abnormality or develop secondary to cellular proliferation from cortical vitreous remnants after a partial posterior vitreous detachment, also known as vitreoschisis, or from concurrent diseases (e.g. proliferative diabetic retinopathy) that provide a fibrovascular scaffold for cellular proliferation and contraction. An epiretinal membrane (ERM) is commonly associated with both the vitreofoveal and vitreomacular traction. It has been shown to proliferate from the retinal surface, coursing up the cone of attached vitreous, and then growing along the back surface of the detached perifoveal hyaloid.[9]
ERM is thought to exacerbate VMT by
(i) strengthening vitreomacular adhesion and preventing spontaneous detachment in the short-term, and
(ii) adding to the anterior traction via fibrocellular proliferation and contraction in the long-term.[9]
Vitreopapillary adhesion (VPA) and vitreopapillary traction (VPT) may potentiate or facilitate the vitreomacular tractional forces as well.[13][14][15][16]
Histopathology of VMT specimens shows fibrocellular proliferation consisting of fibrous astrocytes, myofibroblasts, fibrocytes and RPE cells.[11] It usually forms a ‘double membrane’ that bridges the posterior hyaloidal and the retinal interfaces. Transmission electron microscopy of VMT specimens has confirmed the presence of myofibroblasts, RPE cells, fibrocytes and macrophages, and recognized two distinct types of VMT:
(i) a multilayer of fibrocellular tissue (ERM) proliferating into native vitreous collagen and
(ii) a monolayer of cells proliferating along the ILM directly.[17][18]
The distinction of these two types of ERM are thought to be determined by the presence or absence of vitreoschisis which leaves behind cortical vitreous remnants on the epiretinal surface.[18] Bone marrow derived progenitor cells may contribute to VMT as well.[11][17]
Diagnosis
History
VMT syndrome can affect either sex, although women have a slightly higher incidence presumably from the postmenopausal low-estrogen state that causes premature vitreous liquefaction and earlier onset of PVD. It can occur at any age, and in individuals of any race.[11]
Physical Examination
Slit lamp biomicroscopy with a fundus contact lens or a higher magnification indirect lens may show a faintly visible, taut, and glistening translucent membrane, showing residual adhesion to the central macula.[19] The adhesion may be multifocal and variable in shape.[9]
The vitreofoveolar traction has a smaller diameter of adhesion than the classic VMT. Other associated findings can include macular puckering, varying degrees of macular edema and tractional macular detachment.[9] The course of retinal vessels may be distorted from tractional changes.[20]
Signs
Following signs may be noted clinically:
- Cystic changes in the macula, including tractional CME: 81% have cystic macular changes ranging from isolated cyst to diffuse cystoid changes.[21]
- Epiretinal membrane: 40-100% eyes with VMT have an ERM (depending on whether the ERM is detected by biomicroscopy, OCT or electron microscopy)[11][17][22][23]
- Thickened and taut posterior hyaloid[17]
- Subretinal/subfoveal fluid
- When it occurs concurrently with other diseases (e.g. exudative age-related macular degeneration, proliferative diabetic retinopathy, etc.), findings specific to those diseases may be noted.
Complications can include:
- Full thickness macular hole
- Tractional macular schisis
- Tractional foveal/macular detachment
Symptoms
VMA: Asymptomatic VMT: Symptomatic with blurred or reduced vision, metamorphopsia, micropsia, scotoma, and difficulties with daily vision-related tasks such as reading.[8][11] Onset and progression of symptoms are usually gradual, except in a few cases of sudden onset of vision loss/scotoma due to severe traction causing foveal detachment.[11]
Clinical Diagnosis
Diagnosis is usually confirmed by ancillary testing, most importantly optical coherence tomography.
Ancillary tests
Optical coherence tomography
Optical coherence tomography (OCT) allows noninvasive visualization and imaging of vitreomacular interface and is an important tool in the diagnosis and management of VMT syndrome, especially with the advent of non-surgical management with pharmacologic vitreolysis. The OCT in VMT demonstrates a partial posterior vitreous detachment with persistent vitreous attachment to the fovea alone or in addition to the macula and/or the optic disc margin. The posterior hyaloid usually appears as a hyperreflective and thickened line/band on OCT located posterior to the hyporeflective vitreous and anterior to the retina. The appearance of VMT is accentuated when the sensitivity if the image is increased (by making the image lighter in the OCT machine). It courses in a conical pattern posteriorly to attach to the macula.[11][17] According to Chang et al., the hyperreflective band corresponds to the bridging fibrocellular proliferative tissue.[17]
Underlying morphological alterations such as
- blunting of foveal contour,
- distortion of foveal contour,
- elevation of fovea from the RPE,
- intraretinal edema,
- pseudocystic and cystic changes in the macula with intervening columns of preserved tissue (possibly representing Müeller cells),
- disruption of the inner and outer retinal layers which may include the photoreceptor layer,
- cystoid macular edema,
- full thickness macular hole,
- macular retinoschisis, and
- tractional retinal detachment can be seen on the OCT scan.
The outer retina (the external limiting membrane and the photoreceptors) may appear intact in VMT.[7] This may account for discordance between relatively good visual acuity but severe inner retinal layer distortion/changes seen on OCT.[7] Irrespective of visual acuity, subtle changes may be seen on SD-OCT even in the outer retina. For example – Tsunoda et al. described the ‘cotton ball sign’ which is defined as a round or diffuse, highly-reflective region at the center of the fovea between the inner segment/outer segment line (ellipsoid portion) and the photoreceptor tips on SD-OCT.[24] This sign was present in 7 of 7 cases of VMT and in most cases of FTMH.[24] It may be an indicator of anterior traction on the fovea.[24] Other findings associated with VMT may include a lamellar hole, an epiretinal membrane, an operculum that remains semi-attached to the retina.[8]
The International Vitreomacular Traction Study Group definitions and classifications mentioned above are a recent attempt to standardize terminologies. However, the present knowledge about the OCT features of VMT has evolved over time. Yamada and Kishi[25] studied the tomographic features and described two types of vitreous traction profiles in VMT:
- (i) V shaped - the vitreous cortex is detached from the retina both temporal and nasal to the fovea, and attached only to the fovea, and
- (ii) J shaped[11] or arc shaped - the vitreous cortex is detached from the retina temporal to the fovea, but remains attached to the retina nasal to the fovea and to the fovea itself.
Other studies have differentiated similarly, between a narrow focal foveolar adhesion (vitreofoveolar traction, a subtype of VMT) causing tractional cystoid macular edema versus a broad macular adhesion (classic VMT) which often has a dumbbell shaped configuration and spans several disc diameters in size, with both types being equally prevalent.[9]
Johnson has graded VMT with a vitreofoveal adhesion
- ≤500 μm as vitreofoveolar traction syndrome and
- that around 1500 μm as classic VMT syndrome.[9]
Although the V shaped configuration corresponds to focal VMT and J shaped configuration to broad VMT in the majority, Bottós et al. reported a few cases with V-shaped morphology, but broad adhesions. Based on their anatomic and visual evolution similar to broad VMT, it has been suggested that the diameter of adhesion, and not its pattern, be used to prognosticate. Along the same lines, Spaide et al. have reported a correlation between diameter of vitreofoveal adhesion and macular distortion.[12]The V shaped VMT (also called the vitreofoveolar traction[9]) was commonly associated with tractional foveal detachment preoperatively and a favorable surgical outcome (anatomic and visual restoration).[25] The arc shaped VMT was commonly associated with an absence of foveal detachment (presumably from a weaker but chronic tractional force) and presence of prominent cystoid macular edema preoperatively, and had unfavorable surgical outcome, with progression to macular hole or atrophy despite release of traction by vitrectomy.[25] The associations noted with V- and J-shaped VMT are now modified: focal VMT is commonly associated with CME (89%), impending and full thickness macular holes (61%) and tractional foveal detachment (17%) in contrast to broad VMT that is associated with diffuse retinal thickening (72%), ERM (94%), and less commonly, CME (44%) and macular holes (6%).[11]
The OCT may also show the vitreous to be adherent to the optic disc margins, a condition specifically referred to as vitreopapillary adhesion (VPA),[13][15][16] that can result in vitreopapillary traction (VPT).[14] These may occur independently, but commonly coexist with VMA/VMT.
VMA in symptomatic patients has been graded based on SD-OCT:
- Grade 1: incomplete cortical vitreous separation with attachment at the fovea
- Grade 2: Grade 1 findings plus intraretinal cysts or clefts
- Grade 3: Grade 2 findings plus subretinal fluid.[26]
- However, these will fall under the definition of VMT as per 'the International Vitreomacular Traction Study Group' classification.
While some authorities differentiate between asymptomatic and symptomatic VMA, with the latter showing minor traction on OCT as indicated by photographic standards,[7][26] most agree that the term VMA should be reserved for asymptomatic cases without any OCT abnormalities, and VMT should replace ‘symptomatic VMA’ cases.[8] Other terminologies such as ‘asymptomatic VMT’[7] are also not widely accepted. Regular OCT monitoring is recommended in patients with metamorphopsia or scotoma to detect cases where focal VMA has progressed to VMT and to quantify features of VMT and/or FTMH.[8]
En-face imaging of VMT using coronal C-scans from OCT shows sigmoid shaped hyperreflective bands within the hyporeflective vitreous. The exact sites of vitreomacular attachment in relation to the optic disc, macula, and the vascular arcades can be traced by overlay of C-scan OCT images on red-free confocal images.[27] Spectral domain OCT with three-dimensional (3D) image reconstruction also assists in detailed visualization of VMT morphology including other features such as an associated ERM.[23]
(The morphology of VMT as demonstrated with 3D OCT is well-illustrated in the above video: Courtesy of Dr. Carl Glittenberg;
available at: http://www.youtube.com/watch?v=WAoAUlkbMKU)
Interestingly, about 70% of fellow eyes in patients with VMT have some evidence of vitreomacular interface abnormality noted on OCT, including ERM (40%), VMA (15%), VMT (10%), and lamellar macular hole (5%).[28] This may denote a more widespread abnormality in the components that make up the vitreous.
Fluorescein angiography
Fundus fluorescein angiography may demonstrate retinal capillary leakage in the macula and leakage at the optic disc.[20] Isolated VMT with pseudocyst may not show leak on fluorescein angiogram. Capillary leakage may be present in chronic CME from broad VMT and absent or minimal in CME from focal vitreofoveolar traction.[11] An associated shallow retinal detachment may be noted as fluorescein pooling.[20]
Dynamic B-scan ultrasonic examination
B-scan ultrasound using 10 and 20 MHz frequencies may be used to evaluate for partial posterior vitreous detachment which is seen as a thin, smooth, continuous membrane with focal attachment with minimal after-movement anterior to the retinal surface.[19] It lacks the complete PVD and the Weiss ring differentiating it from ERM.[11]
Partial posterior vitreous detachment as demonstrated with dynamic B-scan ultrasound is well illustrated in the above video: Courtesy of Youtube user Ophthalmicedge; available at http://www.youtube.com/watch?v=0iRCpHZhXao)
Differential diagnosis
The differential diagnosis can include:[11]
- Early full thickness macular hole
- Pseudophakic CME
- Other causes of CME (uveitis, diabetic macular edema, exudative age related macular degeneration, macular telangiectasia)
- ERM
Disease monitoring
Routine self-assessment by Amsler grid evaluation may be advised for patients with this spectrum of disease identified on routine imaging for other indications.
Management
Observation
The natural history of VMT syndrome with observation over a median follow-up of 5 years by Hikichi et al. showed that the visual acuity declined by two or more Snellen lines in 64%, cystoid changes persisted in 67%, and new cystoid changes appeared in 17% of the eyes.[21] Resolution of VMT by means of a spontaneous complete PVD was infrequent, occurred in only 11% of eyes at a median duration of 15 months, and was associated with resolution of cystoid changes and visual improvement in them.[21] Based on these findings, earlier traction release (as opposed to observation) is recommended for treatment of VMT syndrome. Observation may be warranted in rare cases that have spontaneously evolved to complete PVD and have resolving macular changes (from prior VMT).[11]
A recent SD-OCT evolution study by John et al. of ‘symptomatic VMA’ (or VMT) patients showed that over a mean follow-up of 23 months, spontaneous release occurred in 30% of ‘grade 1 VMA’, 30% of ‘grade 2 VMA’, and 57% of ‘grade 3 VMA’ patients, while worsening of SD-OCT features occurred in 16% of ‘grade 1 VMA’, 14% of ‘grade 2 VMA’ and 28% of 'grade 3 VMA’.[26] (Refer to the section on OCT under Ancillary Tests above for the definitions.) A higher rate of spontaneous PVD noted in this natural history study using SD-OCT is most likely related to detection and inclusion of patients with early VMA/VMT compared to the previous study by Hikichi et al. using clinical biomicroscopy.[21][26] Based on their SD-OCT study, John et al. have suggested that initial observation remains a viable option and may be offered to patients with mild symptoms and VMA/VMT features on SD-OCT, before proceeding to surgical or medical treatments.[26]
Surgery
The persistence of vitreomacular (and commonly, vitreopapillary) attachment is thought to be the major culprit in VMT syndrome. Surgical release of this attachment and resolution of both anteroposterior and tangential traction by means of pars plana vitrectomy (PPV) with or without ERM peeling is a common treatment for VMT syndrome.[22] The reconstitution of retinal architecture is expected to occur with time, after removal of the tractional forces. Symptomatic and visual improvements are expected to follow. Outcomes are variable depending on morphology and duration.
PPV is an effective surgical therapy for VMT resulting in a gain of two or more Snellen lines of visual acuity in 45% to 100% of eyes.[19][22][28][29] The mean visual acuity was shown to improve significantly from 20/122 to 20/68 postoperatively associated with reduction of mean foveal thickness from 404 μm preoperatively to 251 μm in one case series. The success of surgery may depend on the preoperative morphologic factors, with the narrow or V shaped VMT (or focal vitreofoveolar traction),[25] focal perifoveal VMT,[28] and tractional CME[19][28] have better visual outcomes. The broad or arc shaped VMT (or classic VMT),[25] vitreous attachment to macula and papillomacular bundle,[30] VMT with lamellar separation of inner from outer foveal layers (macular schisis),[28] prominent CME, chronic retinal detachment, and premacular fibrosis have worse visual outcomes.[11] Shorter duration of symptoms (less than a 6-month duration)[31] and thinner central macular thickness preoperatively correlate with better visual outcome after surgery.[30] Eyes with pre-operative visual acuity of 20/100 or better had better visual outcomes than those worse than 20/100.[32] Post-operative follow-up with serial OCTs may help predict visual outcome.[33] Restoration of inner and outer retinal layers occurs slowly over at least 12 post-operative months as noted on spectral domain OCT and correlates well with visual outcome.[33] On the other hand, resolution of retinal surface folds (occurring within 1 month) and a marked reduction in central retinal thickness and retinal volume (occurring within next 3 months) do not correlate with visual outcome.[33]
Vitrectomy may be combined with one or more additional interventions including stripping of the posterior hyaloid, ERM peeling, ILM peeling, air-fluid exchange, and gas or air endotamponade.[25][28] Adjunctive staining of vitreous with triamcinolone acetonide, ERM with trypan blue, or ILM with indocyanine green/brilliant blue is used per surgeon discretion.[11] During surgery, it is important to create a discontinuity in the posterior vitreous face all around the fovea (or to isolate the VMT from surrounding vitreous) with the vitreous cutter before the induction of PVD. This reduces the risk of causing iatrogenic macular hole during surgery.
Postoperative face-down positioning may be recommended in cases where gas endotamponade is used, typically to attempt to mechanically flatten the retina or to protect against or immediately treat the possibility of a macular hole. Complications of surgery include cataract, new or residual ERM, full thickness macular hole, lamellar macular hole, persistent CME, persistent subretinal fluid, macular atrophy, retinal breaks, retinal pigment epithelial damage, visual field defects, glaucoma, endophthalmitis, and hypotony.[11][19][22][25][28]
Asymptomatic patients found to have VMA are not candidates for surgical therapy.[8]
Medical therapy
The medical therapy of VMT consists of pharmacologic vitreolysis.
The vitreoretinal interface consists of the vitreous cortex attached to the internal limiting membrane of the retina by means of several extracellular matrix proteins such as laminin, fibronectin, and certain collagens (types VI, VII, XVIII).[34][35] Ocriplasmin (formerly, microplasmin) is a recombinant truncated form of human plasmin that has proteolytic activity against these proteins anchoring the vitreoretinal interface. More importantly, ocriplasmin lacks activity against type IV collagen, an important component of ILM, which allows targeted action at the vitreoretinal interface without significant retinal toxicity.[11] It also causes vitreolysis by its activity on native collagens in the vitreous. Jetrea (ThromboGenics, Inc., Iselin, NJ), the active component of which is ocriplasmin, can be administered via intravitreal injection for pharmacologic vitreolysis. Two large randomized controlled phase 3 clinical trials, MIVI-TRUST (Microplasmin for Intravitreous Injection – Traction Release without Surgical Treatment), compared intravitreal injection of 125 μg/0.1 ml ocriplasmin versus (vs) placebo and found statistically significantly higher rates of resolution of pathology with ocriplasmin injection, including resolution of vitreomacular adhesion in 26.5% vs 10.1% eyes, total posterior vitreous detachment in 13.4% vs 3.7%, macular hole closure in 40.6% vs 10.6% of eyes at day 28, and visual gain ≥ 3 lines occurred in 12.3% vs 6.4% of eyes at month 6.[36] Ocular adverse events (usually considered transient) such as floaters, photopsia, injection-related eye pain, or conjunctival hemorrhage occurred in 68.4% vs 53.5% of eyes.[36] There have been concerns raised regarding ocular adverse events such as retinal tear/detachment and significant unexplainted short term vision loss which did recover in all cases, although very rare. The U.S. Food and Drug Administration approved Jetrea for the treatment of patients with symptomatic VMA (i.e. VMT).[37] The European Medicines Agency has approved Jetrea for the treatment of patients with VMT alone or VMT with concurrent FTMH of diameter ≤ 400 μm.[38] Asymptomatic VMA is not an indication for ocriplasmin use.[36] It should be noted that vitrectomy may still be required in patients failing ocriplasmin therapy and also in about 20% of the patients successfully treated with ocriplasmin.[39][40] The cost of Jetrea is around $3,950 (https://www.ncbi.nlm.nih.gov/books/NBK195219/).
Other pharmacologic agents that have been investigated include enzymatic agents such as collagenase, chondroitinase, hyaluronidase, dispase, nattokinase, autologous plasmin, plasminogen activators, and non-enzymatic agents such as RGP (arginine-glycine-aspartate) peptides and urea-based Vitreosolve (Vitreoretinal Technologies Inc., Irvine, CA).[41] While many of these have been discredited due to poor efficacy, retinal toxicity, worsening of VMT (via vitreous liquefaction without vitreoretinal dehiscence) or persistent need for surgery, some are still being studied.[41] None of these are available for clinical use at the time of posting this entry.
Additional Resources
- Porter D, Vemulakonda GA. What Is Vitreomacular Traction? American Academy of Ophthalmology. EyeSmart/Eye health. https://www.aao.org/eye-health/diseases/what-is-vitreomacular-traction. Accessed March 20, 2023.
References
- ↑ Irvine SR. A newly defined vitreous syndrome following cataract surgery. Am. J. Ophthalmol. 1953;36(5):599–619.
- ↑ Jaffe NS. Vitreous traction at the posterior pole of the fundus due to alterations in the vitreous posterior. Trans. Am. Acad. Ophthalmol. Otolaryngol. 1967;71(4):642–52.
- ↑ Reese AB, Jones IS, Cooper WC. Macular changes secondary to vitreous traction. Am. J. Ophthalmol. 1967;64(3):Suppl:544–9.
- ↑ Reese AB, Jones IS, Cooper WC. Vitreomacular traction syndrome confirmed histologically. Am. J. Ophthalmol. 1970;69(6):975–7.
- ↑ Duker JS, Kaiser PK, Binder S, et al. The International Vitreomacular Traction Study Group Classification of Vitreomacular Adhesion, Traction, and Macular Hole. Ophthalmology. 2013;120(12):2611–2619.
- ↑ 6.0 6.1 6.2 Ito Y, Terasaki H, Suzuki T, et al. Mapping posterior vitreous detachment by optical coherence tomography in eyes with idiopathic macular hole. Am. J. Ophthalmol. 2003;135(3):351–5.
- ↑ 7.0 7.1 7.2 7.3 7.4 7.5 Jackson TL, Nicod E, Simpson A, Angelis A, Grimaccia F, Kanavos P. Symptomatic vitreomacular adhesion. Retina. 2013;33(8):1503–11.
- ↑ 8.0 8.1 8.2 8.3 8.4 8.5 Stalmans P, Duker JS, Kaiser PK, et al. OCT-BASED INTERPRETATION OF THE VITREOMACULAR INTERFACE AND INDICATIONS FOR PHARMACOLOGIC VITREOLYSIS. Retina. 2013.
- ↑ 9.00 9.01 9.02 9.03 9.04 9.05 9.06 9.07 9.08 9.09 9.10 Johnson MW. Posterior vitreous detachment: evolution and complications of its early stages. Am. J. Ophthalmol. 2010;149(3):371–82.e1.
- ↑ Bottós JM, Elizalde J, Rodrigues EB, Maia M. Current concepts in vitreomacular traction syndrome. Curr. Opin. Ophthalmol. 2012;23(3):195–201.
- ↑ 11.00 11.01 11.02 11.03 11.04 11.05 11.06 11.07 11.08 11.09 11.10 11.11 11.12 11.13 11.14 11.15 11.16 11.17 Bottós J, Elizalde J, Arevalo JF, Rodrigues EB, Maia M. Vitreomacular traction syndrome. J. Ophthalmic Vis. Res. 2012;7(2):148–61.
- ↑ 12.0 12.1 Spaide RF, Wong D, Fisher Y, Goldbaum M. Correlation of vitreous attachment and foveal deformation in early macular hole states. Am. J. Ophthalmol. 2002;133(2):226–9.
- ↑ 13.0 13.1 Sebag J, Wang MY, Nguyen D, Sadun A. Vitreopapillary adhesion in macular diseases. Trans. Am. Ophthalmol. Soc. 2009;107:35–44.
- ↑ 14.0 14.1 Hedges TR, Flattem NL, Bagga A. Vitreopapillary traction confirmed by optical coherence tomography. Arch. Ophthalmol. 2006;124(2):279–81.
- ↑ 15.0 15.1 Romano MR, Vallejo-Garcia JL, Camesasca FI, Vinciguerra P, Costagliola C. Vitreo-papillary adhesion as a prognostic factor in pseudo- and lamellar macular holes. Eye (Lond). 2012;26(6):810–5.
- ↑ 16.0 16.1 Wang MY, Nguyen D, Hindoyan N, Sadun A a, Sebag J. Vitreo-papillary adhesion in macular hole and macular pucker. Retina. 2009;29(5):644–50.
- ↑ 17.0 17.1 17.2 17.3 17.4 17.5 Chang LK, Fine HF, Spaide RF, Koizumi H, Grossniklaus HE. Ultrastructural correlation of spectral-domain optical coherence tomographic findings in vitreomacular traction syndrome. Am. J. Ophthalmol. 2008;146(1):121–7.
- ↑ 18.0 18.1 Gandorfer A, Rohleder M, Kampik A. Epiretinal pathology of vitreomacular traction syndrome. Br. J. Ophthalmol. 2002;86(8):902–9.
- ↑ 19.0 19.1 19.2 19.3 19.4 Johnson MW. Tractional cystoid macular edema: a subtle variant of the vitreomacular traction syndrome. Am. J. Ophthalmol. 2005;140(2):184–92.
- ↑ 20.0 20.1 20.2 AAO. Diseases of the Vitreous and the Vitreoretinal Interface. In: Retina and Vitreous. Section 12. Basic and Clinical Science Course.; 2013:302–4.
- ↑ 21.0 21.1 21.2 21.3 Hikichi T, Yoshida A, Trempe CL. Course of vitreomacular traction syndrome. Am. J. Ophthalmol. 1995;119(1):55–61.
- ↑ 22.0 22.1 22.2 22.3 McDonald HR, Johnson RN, Schatz H. Surgical results in the vitreomacular traction syndrome. Ophthalmology. 1994;101(8):1397–402.
- ↑ 23.0 23.1 Koizumi H, Spaide RF, Fisher YL, Freund KB, Klancnik JM, Yannuzzi L. Three-dimensional evaluation of vitreomacular traction and epiretinal membrane using spectral-domain optical coherence tomography. Am. J. Ophthalmol. 2008;145(3):509–517.
- ↑ 24.0 24.1 24.2 Tsunoda K, Watanabe K, Akiyama K, Usui T, Noda T. Highly reflective foveal region in optical coherence tomography in eyes with vitreomacular traction or epiretinal membrane. Ophthalmology. 2012;119(3):581–7.
- ↑ 25.0 25.1 25.2 25.3 25.4 25.5 25.6 Yamada N, Kishi S. Tomographic features and surgical outcomes of vitreomacular traction syndrome. Am. J. Ophthalmol. 2005;139(1):112–7.
- ↑ 26.0 26.1 26.2 26.3 26.4 John VJ, Flynn HW, Smiddy WE, et al. CLINICAL COURSE OF VITREOMACULAR ADHESION MANAGED BY INITIAL OBSERVATION. Retina. 2013.
- ↑ Forte R, Pascotto F, de Crecchio G. Visualization of vitreomacular tractions with en face optical coherence tomography. Eye (Lond). 2007;21(11):1391–4.
- ↑ 28.0 28.1 28.2 28.3 28.4 28.5 28.6 Witkin AJ, Patron ME, Castro LC, et al. Anatomic and visual outcomes of vitrectomy for vitreomacular traction syndrome. Ophthalmic Surg. Lasers Imaging. 2010;41(4):425–31.
- ↑ Smiddy WE, Michels RG, Glaser BM, deBustros S. Vitrectomy for macular traction caused by incomplete vitreous separation. Arch. Ophthalmol. 1988;106(5):624–8.
- ↑ 30.0 30.1 Sonmez K, Capone A, Trese MT, Williams GA. Vitreomacular traction syndrome: impact of anatomical configuration on anatomical and visual outcomes. Retina. 2008;28(9):1207–14.
- ↑ Davis RP, Smiddy WE, Flynn HW, Puliafito CA. Surgical management of vitreofoveal traction syndrome: optical coherence tomographic evaluation and clinical outcomes. Ophthalmic Surg. Lasers Imaging. 2010;41(2):150–6.
- ↑ Koerner F, Garweg J. Vitrectomy for macular pucker and vitreomacular traction syndrome. Doc. Ophthalmol. 1999;97(3-4):449–58.
- ↑ 33.0 33.1 33.2 Sayegh RG, Georgopoulos M, Geitzenauer W, Simader C, Kiss C, Schmidt-Erfurth U. High-resolution optical coherence tomography after surgery for vitreomacular traction: a 2-year follow-up. Ophthalmology. 2010;117(10):2010–7, 2017.e1–2.
- ↑ Kohno T, Sorgente N, Ishibashi T, Goodnight R, Ryan SJ. Immunofluorescent studies of fibronectin and laminin in the human eye. Invest. Ophthalmol. Vis. Sci. 1987;28(3):506–14.
- ↑ Ponsioen TL, van Luyn MJ a, van der Worp RJ, van Meurs JC, Hooymans JMM, Los LI. Collagen distribution in the human vitreoretinal interface. Invest. Ophthalmol. Vis. Sci. 2008;49(9):4089–95.
- ↑ 36.0 36.1 36.2 Stalmans P, Benz MS, Gandorfer A, et al. Enzymatic vitreolysis with ocriplasmin for vitreomacular traction and macular holes. N. Engl. J. Med. 2012;367(7):606–15.
- ↑ FDA News Release. FDA approves Jetrea for symptomatic vitreomacular adhesion in the eyes. 2012. Available at: http://www.fda.gov/NewsEvents/Newsroom/PressAnnouncements/ucm324369.htm.
- ↑ European Medicines Agency. European Medicines Agency - Human Medicines - Jetrea. 2013;1(January). Available at: http://www.ema.europa.eu/docs/en_GB/document_library/Summary_of_opinion_-_Initial_authorisation/human/002381/WC500137451.pdf.
- ↑ US Food and Drug Administration Center for Drug Evaluation and Research. Medical review(s). 2012. Available at: http://www.accessdata.fda.gov/drugsatfda_docs/nda/2012/125422Orig1s000MedR.pdf.
- ↑ Syed YY, Dhillon S. Ocriplasmin: A Review of Its Use in Patients with Symptomatic Vitreomacular Adhesion. Drugs. 2013:1617–1625.
- ↑ 41.0 41.1 Schneider EW, Johnson MW. Emerging nonsurgical methods for the treatment of vitreomacular adhesion: a review. Clin. Ophthalmol. 2011;5:1151–65.